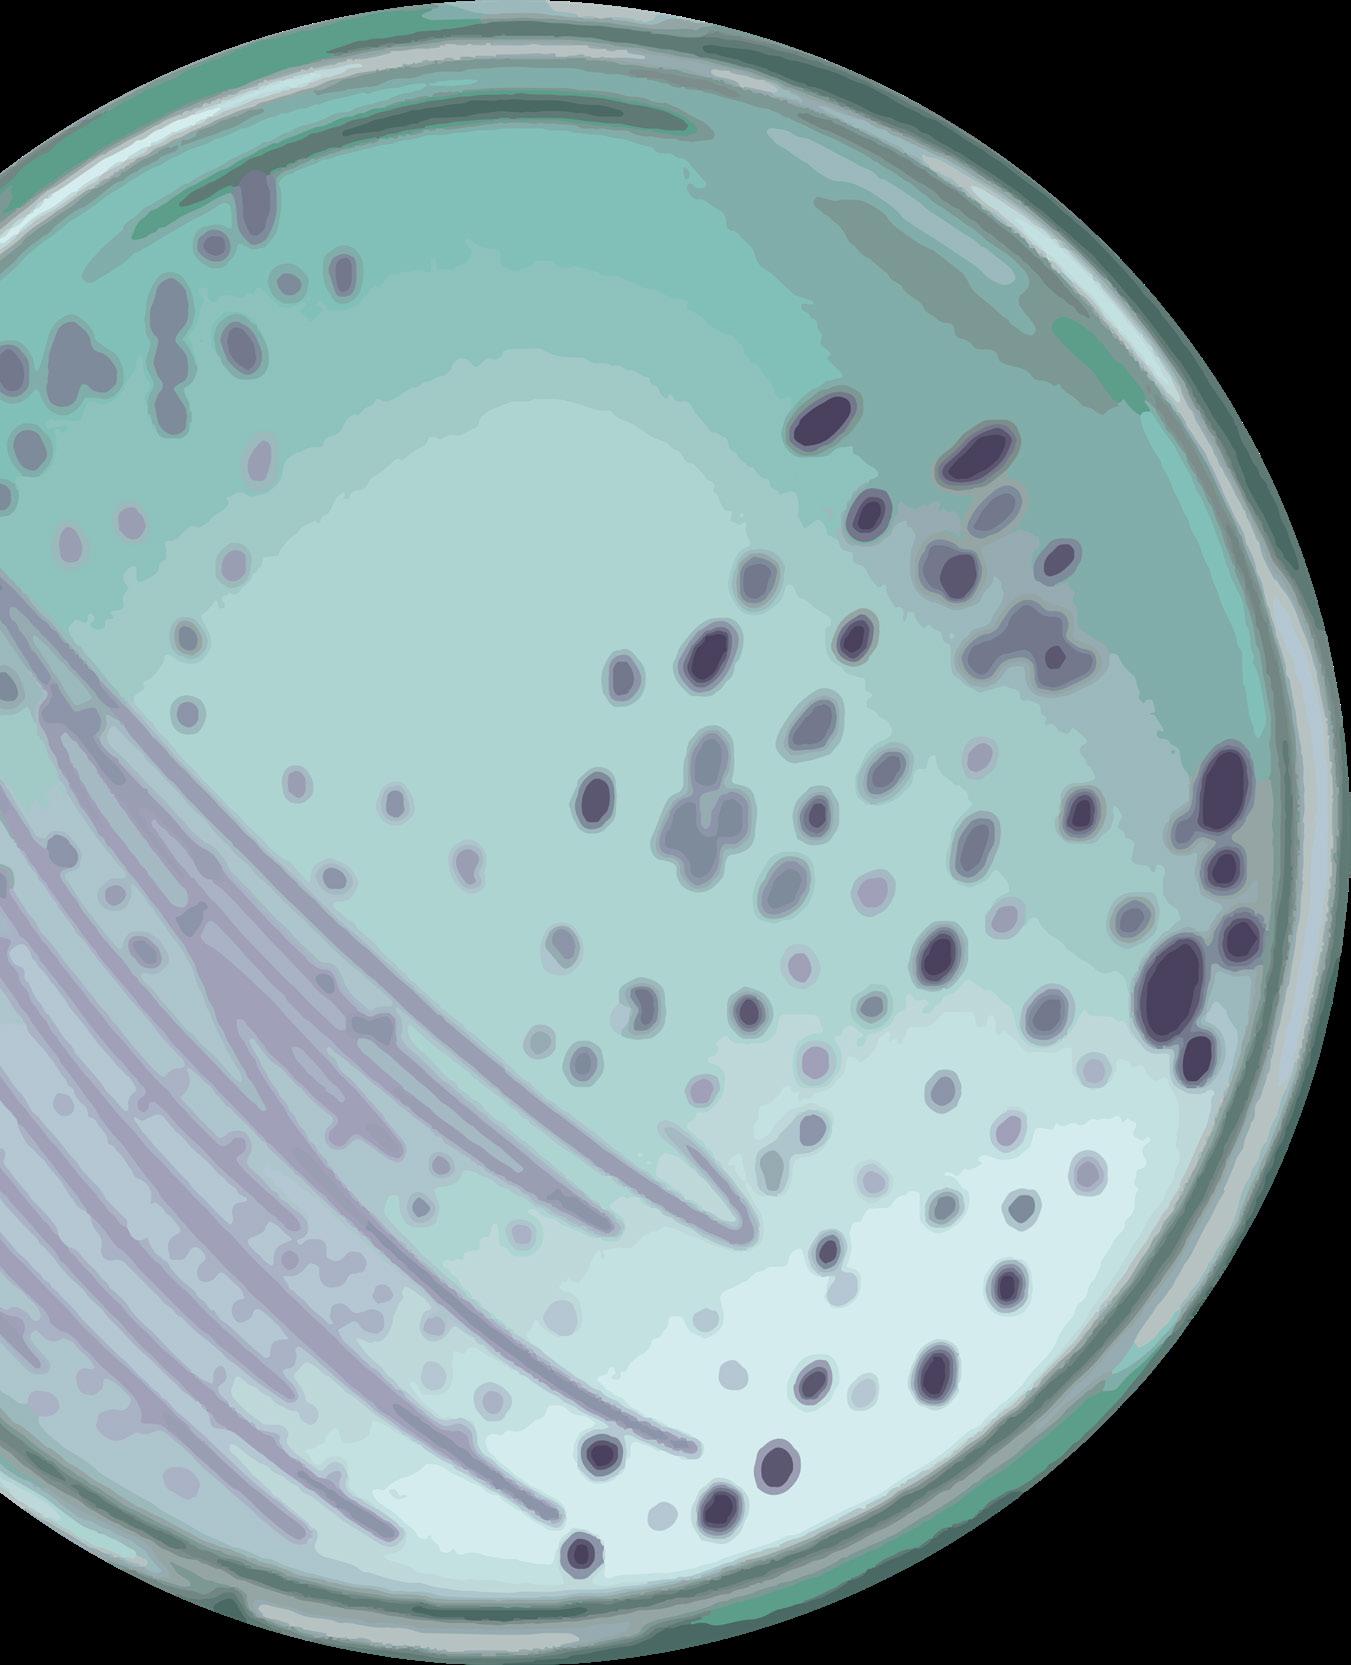

19 minute read
Brain Mapping & Music Therapy Linked to Postoperative Success
JOSHUA TALABUCON `25
Introduction
Advertisement
Art has the power to captivate, heal, and change the human perspective. For example, Picasso’s Guernica is a harrowing depiction of the horrors of war, while Spielberg’s Jurassic Park enchants its audience by bringing dinosaurs to life. While these works may seem different, they both utilized technology to share a message with the audience. Without paint, Picasso could not depict war in such a unique and abstract way. Similarly, without the development of film, cameras, audio equipment, and CGI, Spielberg would not have been able to bring extinct dinosaurs to life. Today, virtual reality (VR), or any technology that enables a user to experience and interact with a fully digital environment, is at the forefront of development (1). VR technology enables artists and audiences to engage and create works that can generate interest, heal, and change the human perspective. Currently, there is an immense interest in its applications in the art and healthcare industries. With this tool, artists can create works that spark interest, create safe spaces for patients to explore who they are, and even push the physical limits of patients in physical therapy.
How VR Changes the Art Scene
VR’s fully digital environment enables artists to create immersive experiences. VR’s immersiveness comes from its ability to exploit the senses. The headset mimics human vision by creating a sense of depth, tracking head movement, and controlling the field of view. Headphones help block outside noise and relay sounds from the virtual world. Users can also use controllers to interact with the digital environment. By engaging the senses, the audience is immersed in the digital environment. As a result, the audience can explore and interact with artwork intimately, forging a closer connection between the audience and the work. To better understand how this connection may be forged, a team of researchers led by Dr. Raya from the Technical University of Madrid and the University of Technology, Arts, and Design in Madrid investigated tools that foster an interest in art in young people (2). The team created immersive, navigable, 3D replicas of Salvador Dali’s The Persistence of Memory and Hieronymus Bosch’s Garden of Earthly Delights (2). Both pieces utilized immersive sound design, which entails a 3D soundscape that interacts with the user based on the user’s position in the virtual environment. The Persistence of Memory utilized the sound of the sea and a ticking clock to transport its audience to the coast, while the Garden of Earthly Delights featured sounds of fire, crows, and cows to immerse the audience in the otherworldly environment (2). The Persistence of Memory also used a special controller that allowed users to “feel” certain surfaces, such as the curvature of a clock and the coarseness of the sand (2). Next, the team recruited 66 university students with varying majors and asked them to view a painting using one of three mediums: an illustrated book, an audio-visual presentation, or the VR environment. After viewing the painting, participants filled out an anonymous questionnaire rating their satisfaction, desire to repeat the experience with the same piece of art, and desire to repeat the experience with another piece of art on a scale of 1 to 5 (2). Analysis of the questionnaire revealed that participants enjoyed the virtual environment the most, with average ratings of 4.25 for the virtual environment, 3.96 for the audio-visual piece, and 3.25 for the illustrated book (2). When asked about their desire to repeat the experience with the same piece, participants gave VR an average of 4.40 against a 3.82 and 3.29 for the audio-visual piece and illustrated book, respectively (2). Finally, when rating their desire to repeat the experience with a different piece, participants gave VR a rating of 4.95 against a 4.36 and 4.12 for the audio-visual piece and illustrated book, respectively (2). Additionally, the results suggested that 90% of the participants who used VR favored using it on another piece of art (2).
The study showed that VR’s immersiveness generated a closer connection between the audience and the piece, as reflected by the desire to repeat the experience. Another factor that aided in VR’s success was its interactiveness. Unlike the audio-visual piece or the illustrated book, the virtual environment allowed users to “walk around” the piece at their own pace. Moreover, because the piece was 3D, users could see various elements from different angles. When this is combined with the sound and feel of the elements, users begin to physically experience the piece. Therefore, by using VR as a platform to broadcast art, artists can bridge the gap between the physical and mental experience of art; the audience not only sees a painting, but can also experience the work.
VR and Art Therapy
While VR art can create stronger connections between artists and the audience, it can also be used as a potential form of mental therapy. Researchers led by graduate student Irit Hacmun from the University of Haifa and Bar-Ilan University conducted a study to determine the effectiveness of VR as a potential tool in art therapy. The researchers recruited seven art therapists with at least 17 years of experience in treating a variety of patients within Israel for the study (3). Each therapist was given a ten-minute overview of the VR apparatus, followed by 50-minute and 30-minute sessions to create a piece and observe another piece, respectively (3). Researchers interviewed each therapist for 90 minutes at the conclusion of the study. Qualitative data was collected regarding the participants’ thoughts on the experience and VR’s potential as a tool for art therapy (3). After the interviews, the team found unanimous agreement amongst the therapists that art therapy via VR was a viable treatment method that could be scaled up for patients without detracting from the therapist-patient relationship. When asked about the impact of VR on the patient experience, the therapists agreed that VR’s immersiveness and first-person perspective could be used to detach patients from reality and allow them to focus inward. As a result, they concluded that patients could create works
Figure 1 Researchers created a 3D virtual painting of Hieronymus Bosch’ s Garden of Earthly delights in an attempt to foster an art interest in young adults.

of their own volition without fear or reprimand (3). Likewise, immersion also gave the therapists a sense of empowerment, promoting confidence and openness, which could be a transferable sentiment experienced by patients as well. The therapists also found that VR was flexible; participants could undo mistakes, erase, change, and cancel actions. The flexibility and freedom in VR could give patients unmatched control and a sense of independence. However, they agreed that VR art therapy should be used in conjunction with a wide range of other treatments, especially as VR’s freedom and immersiveness can lead to a potentially overwhelming overflow of emotions (3). According to most therapists in the study, VR art therapy could be applicable for a wide audience with a particular focus on patients with high anxiety, children, and adolescents, especially as children and adolescents have a greater ability to adapt to technology (3). Overall, the study highlighted VR’s immersiveness, first person perspective, and interactivity as factors that suggest its success as a tool for art therapy. By using this fully digital environment, participants have greater freedom to express themselves, and thus can experience reductions in stress or anxiety.
VR and Physical Therapy
Researchers also explored the applications of VR to physical therapy. Physical therapy aims to ease pain and improve function of an affected area through movement. Because VR art therapy uses a 3D interface, artists must physically exert multiple parts of the body to create 3D works of art. For some patient populations, such as those suffering from stroke, VR’s physical nature can be manipulated to improve movement and function. In particular, a team of researchers under Dr. Marylyn Alex from the University of Auckland conducted a study to compare the effects of VR art therapy with that of traditional art therapy in stroke patients. The team conducted a field study and a technological study using the same group of patients. The field study, which ran for a total of three weeks, consisted of a weekly in-person class that lasted two hours and 30 minutes. In this class, researchers split participants among tables in groups of three to four. Such an environment simulated a casual setting in which participants could paint and socialize (4). While the participants engaged in the activities, researchers took photos and notes of the participants’ work with a focus on inspiration, accomplishment, physical aspect, and social aspect. The technological study, on the other hand, consisted of a single session in which patients were placed in a room with two controllers and a headset (4). Researchers explained the workings of the system, and gave participants 35 minutes to create an image, providing assistance with controllers when necessary (4). At the end of the session, researchers asked participants about their intentions, the characteristics of the VR paint, the impact of immersiveness, the physical aspect, and the degree of control (4). In both instances, patients felt a deeper sense of accomplishment due to the ability to create meaningful pieces via art therapy. However, the researchers noted that painting in VR necessitated a broader range of movements, such as swiveling or twisting one’s body to access more blank spaces. With these results in mind, researchers concluded that physical therapy via VR was an effective treatment option for patients with stroke with some limitations. While the physical aspects of a 3D environment helped participants with their work, the participants’ ability to express themselves was limited to their physical abilities. Those who could not use their full upper body felt constrained and frustrated, while those with full upper body mobility enjoyed the experience. The group proposed changes to make it easier for therapy such as making controllers that feel and act like actual brushes. Regardless, the interactive interface and 3D environment of VR still encourage physical exertion. Furthermore, improvements to the technology can help refine the treatment for additional patient populations in need of physical therapy.


The Future of VR Art
Both VR and VR art are still in their infancy. However, new program development is already underway to broaden the scope of VR in art and healthcare. One example is the art program Tilt Brush. Tilt Brush is a 3D virtual art program developed by Google that enables users to create works within a room-sized 3D space (5). Unlike other programs, Tilt Brush offers an unmatched degree of freedom. Additionally, Tilt Brush is widely accessible through Steam, Vive, Oculus, Humble Store, and PlayStation Store. To investigate the potential applications for Tilt Brush, Ying-Chung, Lui, and Chang Chwen-Liang from Shih Hsin University interviewed 8 art therapists, two of whom were professional counselors and another two who were art therapy researchers (6). The therapists noted that Tilt Brush is highly immersive and reliant on first-person perspectives, creating a safe space for patients. Additionally, because it is fully digital, the environment can be altered to the patient's needs. In the study, these elements aided in calming the patient and helping them focus on creating a work. One therapist also noted that Tilt Brush’s 3D environment created a highly interactive space, allowing patients to express themselves physically and artistically. Finally, therapists mentioned that adolescents had the most success because of their technological proficiency. By being in a safe space with familiar tools, adolescent patients were able to express themselves and build self confidence. Because this program is accessible across multiple platforms, it may be possible for an even wider population to access and experience these benefits.
Conclusion
VR is a new technology with an expanding horizon. The interactive nature of VR creates new experiences and changes the way humans experience the world. VR’s immersive and interactive environment engages its audience and helps them experience artwork from a new perspective. The immersive aspect of VR art can also create a safe space for artists to express themselves, which can be used in art therapy treatment. Additionally, the fully digital environment can help stimulate a physical response in patients in physical therapy. As a result, programs such as Google’s Tilt Brush are giving artists and therapists new tools to enhance their work. However, there is still room for improvement. With further research and development, it may be possible to create more personalized spaces for patients that are suitable for each of their needs. Similarly, incorporating more bodily features may allow VR to act as a physical therapeutic agent for patients with different ailments. By expanding this technology globally, artists and patients alike may find that this digital playground offers more than meets the eye.
References
1. Virtual reality vs. augmented reality vs. mixed reality: what you need to know. Intel, (2020). 2. L. Raya, et al., Virtual reality application for fostering interest in art. IEEE Computer Graphics and Applications 41, 106-113 (2021). doi: 10.1109/MCG.2021.3055685. 3. I. Hacmun, D. Regev, and R. Salomon, Artistic creation in virtual reality for art therapy: a qualitative study with expert art therapists. The Arts in Psychotherapy 72, 101745 (2021). doi: 10.1016/j.aip.2020.101745. 4. M. Alex, B. Wünsche, and D. Lottridge, Virtual reality art-making for stroke rehabilitation: field study and technology probe. International Journal of Human-Computer Studies 145, 102481 (2021). doi: 10.1016/j.ijhcs.2020.102481. 5. Tilt Brush by Google. Tilt Brush, (2016). 6. L. Ying-Chun and C. Chwen-Liang, The application of virtual reality technology in art therapy: a case of Tilt Brush. 2018 1st IEEE International Conference on Knowledge Innovation and Invention (ICKII), 47-50 (2018). doi: 10.1109/ ICKII.2018.8569081
Images retrieved from:
1. https://upload.wikimedia.org/wikipedia/commons/thumb/6/6d/The_Garden_of_Earthly_Delights_by_Bosch_High_Resolution.jpg/1599px-The_Garden_of_Earthly_Delights_by_Bosch_High_Resolution.jpg?20121109122020
MICROBIAL PIGMENTS
A Molecular Palette For Art And Medicine

Introduction
The production of colorants, including pigments and dyes used to color materials, dates back to prehistoric times with evidence of natural pigments present on early human tools approximately 400,000 years ago (1). Most modern colorants are now produced synthetically, and are widely used in commercial products such as clothing and food dyes. However, synthetic colorant production releases both greenhouse gasses and water-polluting chemical discharge, contributing to climate change and ecological destruction, respectively (2). Many synthetic colorants have also been found to have mutagenic and carcinogenic effects with long term exposure (2-3). Due to the synthetic colorants’ negative effects on the environment and human health, there has been recent interest in shifting back to natural methods of colorant production. Current research suggests that microbes are a promising source of natural colorants; these pigments present as a safe and sustainable alternative to synthetic colorants, and also show diverse biotherapeutic properties.
Violet Dyes in the Textile Industry
The textile industry is responsible for 60 to 70 percent of dye pro-

c
duction and use; however, an estimated 15 percent of the dyes used in the coloring process are discharged as wastewater, making textiles a significant contributor to water pollution (4). Recent research efforts have focused specifically on finding alternatives to violet dyes such as crystal violet. While known for its genotoxic and carcinogenic effects, crystal violet can also absorb sunlight and inhibit plant photosynthesis when dissolved in water. Consequently, the amount of dissolved oxygen available in aquatic ecosystems decreases, resulting in the death of aquatic life (4). Due to its complex chemistry, crystal violet dye is also difficult to remove once present in ecosystems, making its prohibition an environmental safety priority (4). To address this issue, Dr. Maria Kanelli and a team of researchers from the National Technical University of Athens investigated the efficacy of violacein, a deep violet colored microbial pigment produced by Janthinobacterial lividum, in dyeing polyamide fabrics (5). Researchers first optimized microbial cultivation and extraction of the pigment using bioreactors, or eco-friendly instruments used to grow bacteria due to their convenience in waste containment (6). Over the course of the next six days, three different dyeing methods of polyamide fabric were tested: direct incubation of fabrics with the bacterium in the bioreactor (SFD), exposure of fabric to bacterium-containing medium extracted from the bioreactor (DAFS), and exposure of fabric to a medium that had been sonicated to destroy and remove cells from violacein pigment (DD) (5). At the end of the exposure period, each conditioned fabric was assessed for important commercial dye standards, such as color fastness (the degree to which a dye can leach color and stain surrounding cloths during washing) and color change (the degree to which dyed fabrics have changed in color from their undyed counterparts). Color fastness was measured on a scale of one to five, where five indicated no contrast between the color of a material before and after treatment, and one indicated complete contrast and high color leaching. When measuring color change, a score of one was considered a perceivable change in color of 50% to the naked eye, while a score of two indicated a 100% perceivable change in color. Researchers also assessed abrasion resistance via washes of varying pressures that simulated washing and drying clothes, and also exposed the violacein-stained fabrics to various pH, temperature, pressure, and light conditions to separately assess for their effects on color fastness. For all dyeing methods, color fastness reached a value of five for every condition except intense light exposure, suggesting that there was no leaching of the violacein dye. Assessment of color strength showed that the SFD dyeing method was most effective out of the three tested. Furthermore, SFD scored a ~1.5 (74.81%) in color change, while undyed control fabric scored a zero (5). The results of the experiment are significant as they suggest that violacein can strongly stain fabric and give a noticeable change in color. A high color change score indicates that it takes less dye to achieve the target color change perceivable by an observer. Furthermore, the results of the color fastness tests also show violacein-stained fabric retains the color

found to have mutagenic an d ca r c i n o geni Many synthetic coloran ts hav e a l so b een effects with long term exp os u r e .

change when exposed to washes and harsh conditions. These findings point toward the use of violacein as a safe replacement for synthetic violet dyes, such as crystal violet, in clothing because it does not dissolve easily in water. Additionally, all staining methods were done in the absence of organic solvents, which would otherwise contribute significantly to the discussed textile discharge at the end of the dyeing process, meaning violacein could be eco-friendly to produce and use.
Red Food Coloring from Fungi
In addition to reducing environmental impacts, microbial pigments may also have applications as safer food colorants. Synthetic colorants act as preservatives in some cases and help make consumables more appealing to consumers by artificially changing their color; however, long-term exposure can have detrimental effects on the human body, such as an increased risk of developing tumors (2-3). The failure of producers to regulate these dyes under safe concentrations designated by federal agencies like the Food and Drug Administration (FDA) has yielded great concern in consumers. In contrast, microbial pigments have no known adverse effects with consumption at high concentrations, resulting in rapid FDA approval of several microbial pigments with synthetic counterparts (3). Red pigments from Monascus fungi have been of particular interest. To determine its use as a natural food colorant, Dr. Osama M. Darwesh and his team of researchers from the Egypt Department of Agricultural Microbiology cultured Monascus ruber fungi and isolated a red pigment called OMNRC45. The team first evaluated the biosafety of the pigment via acute toxicity tests with young adult male mice (7). The mice were administered OMNRC45, carmoisine E122 (a synthetic red pigment), or water, with varying dosages ranging from 10 to 5000 mg/kg body weight. The team tested each colorant for its LD50, or the dosage at which it was lethal to 50 percent of the sample population of mice. The mice were also monitored for any signs of toxicity, such as abnormal changes in motor activity, throughout the week-long period of the study. At the end of the week, the mice were dissected, and their organs were examined for damage (7). Analysis of the results indicated that OMNRC45 had no observable detrimental effects on the mice. The LD50 for the positive control synthetic colorant was 4166 mg/kg body weight. 5000 mg/ kg body weight carmoisine E122-fed groups
showed increased male aggression and male and female diarrhea. In contrast, OMNRC45 pigment showed no increased mortality in any of the experimental groups and no observable negative effects compared to the water-fed control group, even at high doses. Additionally, organ dissection analysis found that carmoisine E122-fed mice at higher doses had enlarged and discolored livers, hepatotoxicity, and significant accumulation of carmoisine E122 in all organs. OMNRC45-fed mice showed low accumulation with no abnormalities in extracted organs (7). A sensory assessment wherein lollipops and jellybeans were colored using OMNRC45 pigment was also conducted. A panel judged the appearance and acceptability of the final products and approved OMNRC45 as a suitable pigment for coloring foods and increasing consumer appeal (7). Although carmoisine E122 had been previously approved for use by the FDA in certain foods, OMNRC45 shows promise as a natural alternative based on the results of this study (7). Of most significance is the comparative lack of toxicity in all metrics for OMNRC45 in contrast to carmoisine E122, suggesting OMNRC45 is a safer alternative to synthetic colorants currently in use.
Biotherapeutic Applications of Microbial Pigments
In addition to microbial pigments being sustainable sources of natural colorants and improving human and environmental health, they may also hold value as novel biotherapeutics. Recent studies have found that microbial pigments possess a plethora of biotherapeutic and medicinal properties. There are over 25 diseases that microbial pigments demonstrate possible efficacy for treating, as well as many possible biomedical applications (1). Of most interest are the antimicrobial and anticancer activities of many well characterized microbial pigments. In a recent study, a team of researchers under Dr. Claira Aruldass demonstrated the antimicrobial activity of the violet microbial pigment violacein against Staphylococcus aureus (SA) and methicillin-resistant Staphylococcus aureus (MRSA). The researchers first cultured SA and MRSA in growth plate wells (8). Liquid growth medium containing a compound which turns from clear to pink in the presence of bacterial growth was added on top of the plates into the wells. Each well then received a specific concentration of violacein or vancomycin, a known inhibitor of bacterial growth acting as a positive con trol. e monstrate possible efficacy for t reat i n g . . .T h d ere are over 25 diseases that microbial pi gment s